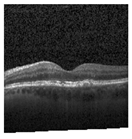
Jimaging 09 00219 i005
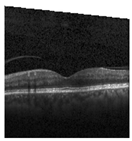
Jimaging 09 00219 i007

Figure 2.
Representative images for diseases.
Figure 2.
Representative images for diseases.
Figure 3.
Illustrative examples from the retinal image dataset are presented. Figure (a) showcasing Choroidal NeoVascularization, characterized by the presence of neovascular membranes (indicated by white arrowheads) along with associated sub-retinal fluid (marked by arrows). Figure (b) illustrates Diabetic Macular Edema, which manifests as intra-retinal fluid associated with retinal thickening (denoted by arrows). Figure (c) displays multiple instances of drusen (highlighted by arrowheads), while Figure (d) illustrates a normal, pristine retina with an undisturbed foveal structure and no signs of retinal fluid or edema.
Figure 3.
Illustrative examples from the retinal image dataset are presented. Figure (a) showcasing Choroidal NeoVascularization, characterized by the presence of neovascular membranes (indicated by white arrowheads) along with associated sub-retinal fluid (marked by arrows). Figure (b) illustrates Diabetic Macular Edema, which manifests as intra-retinal fluid associated with retinal thickening (denoted by arrows). Figure (c) displays multiple instances of drusen (highlighted by arrowheads), while Figure (d) illustrates a normal, pristine retina with an undisturbed foveal structure and no signs of retinal fluid or edema.
Figure 4.
Graphical visualization of the proposed model.
Figure 4.
Graphical visualization of the proposed model.
Figure 5.
Training and Validation Result. (a) represents training and validation accuracy (b) shows training and validation loss.
Figure 5.
Training and Validation Result. (a) represents training and validation accuracy (b) shows training and validation loss.
Figure 6.
Class-wise performance of CNN model.
Figure 6.
Class-wise performance of CNN model.
Figure 8.
The model determined the presence of Drusen in the image by analyzing the OCT image and noting a significant concentration of red pixels (scattered in central regions) in the explanatory image (second in a row), which is located in the second column.
Figure 8.
The model determined the presence of Drusen in the image by analyzing the OCT image and noting a significant concentration of red pixels (scattered in central regions) in the explanatory image (second in a row), which is located in the second column.
Figure 9.
The model’s examination of the OCT image revealed a significant number of red pixels in the explanatory image (third in a row) to suggest the presence of a healthy eye.
Figure 9.
The model’s examination of the OCT image revealed a significant number of red pixels in the explanatory image (third in a row) to suggest the presence of a healthy eye.
Figure 10.
The model determined that the OCT image exhibited indications of CNV, which is a retinal disorder, due to the significant abundance of red pixels in the third explanatory image located in the fourth column.
Figure 10.
The model determined that the OCT image exhibited indications of CNV, which is a retinal disorder, due to the significant abundance of red pixels in the third explanatory image located in the fourth column.
Figure 11.
The model determined that the OCT image indicated the presence of DME due to the significant number of red pixels observed in the fifth column of the fourth explanatory image.
Figure 11.
The model determined that the OCT image indicated the presence of DME due to the significant number of red pixels observed in the fifth column of the fourth explanatory image.
Figure 12.
Training and Validation Results for COVID-19.
Figure 12.
Training and Validation Results for COVID-19.
Figure 13.
Confusion Matrix and ROC for COVID-19.
Figure 13.
Confusion Matrix and ROC for COVID-19.
Figure 14.
The analysis conducted by the model on the X-ray image indicated elevated concentrations of red pixels in the initial explanatory image (located in the second column). These red pixels are likely to represent regions of the image that are suggestive of tuberculosis.
Figure 14.
The analysis conducted by the model on the X-ray image indicated elevated concentrations of red pixels in the initial explanatory image (located in the second column). These red pixels are likely to represent regions of the image that are suggestive of tuberculosis.
Figure 15.
The model’s prediction is based on the presence of a substantial number of red pixels in the second explanatory image, situated in the third column, suggesting that the X-ray image depicts pneumonia.
Figure 15.
The model’s prediction is based on the presence of a substantial number of red pixels in the second explanatory image, situated in the third column, suggesting that the X-ray image depicts pneumonia.
Figure 16.
The model’s forecast of pneumonia was substantiated by the elevated density of red pixels in the third explanatory image.
Figure 16.
The model’s forecast of pneumonia was substantiated by the elevated density of red pixels in the third explanatory image.
Figure 17.
The model determined that the X-ray image was classified as “Normal” because there was a notable concentration of red pixels in the fourth explanatory image.
Figure 17.
The model determined that the X-ray image was classified as “Normal” because there was a notable concentration of red pixels in the fourth explanatory image.
Figure 19.
Training and Validation Result for Kidney Stone.
Figure 19.
Training and Validation Result for Kidney Stone.
Figure 20.
Confusion Matrix and ROC for COVID-19.
Figure 20.
Confusion Matrix and ROC for COVID-19.
Figure 21.
The model found that there were a lot of red pixels in the first explanation image (second column) of the CT scan. These red pixels are likely to be areas of the image that are indicative of a tumor.
Figure 21.
The model found that there were a lot of red pixels in the first explanation image (second column) of the CT scan. These red pixels are likely to be areas of the image that are indicative of a tumor.
Figure 22.
The model’s prediction that the CT image is a cyst is supported by the high concentration of red pixels in the explanation image in the third column.
Figure 22.
The model’s prediction that the CT image is a cyst is supported by the high concentration of red pixels in the explanation image in the third column.
Figure 23.
The model’s prediction of Stone was supported by the high concentration of red pixels in the third explanation image.
Figure 23.
The model’s prediction of Stone was supported by the high concentration of red pixels in the third explanation image.
Figure 24.
The model found that the CT image is predicted as Normal as the high concentration of red pixels is located in the fourth explanation image.
Figure 24.
The model found that the CT image is predicted as Normal as the high concentration of red pixels is located in the fourth explanation image.
Table 1.
The proposed lightweight CNN Model Architecture. Note the “Param #.” represents the parameters involved in the given CNN.
Table 1.
The proposed lightweight CNN Model Architecture. Note the “Param #.” represents the parameters involved in the given CNN.
| Layer (Type) | Output Shape | Param # |
|---|
| Conv2D | (None, 178, 178, 16) | 448 |
| MaxPooling2D | (None, 89, 89, 16) | 0 |
| Dropout | (None, 89, 89, 16) | 0 |
| Conv2D | (None, 87, 87, 32) | 4640 |
| MaxPooling2D | (None, 43, 43, 32) | 0 |
| Dropout | (None, 43, 43, 32) | 0 |
| Conv2D | (None, 41, 41, 64) | 18,496 |
| MaxPooling2D | (None, 20, 20, 64) | 0 |
| Dropout | (None, 20, 20, 64) | 0 |
| Conv2D | (None, 18, 18, 128) | 73,856 |
| MaxPooling2D | (None, 9, 9, 128) | 0 |
| Dropout | (None, 9, 9, 128) | 0 |
| Conv2D | (None, 7, 7, 256) | 295,168 |
| MaxPooling2D | (None, 3, 3, 256) | 0 |
| Dropout | (None, 3, 3, 256) | 0 |
| Flatten | (None, 2304) | 0 |
| Dense | (None, 256) | 590,080 |
| Dense | (None, 4) | 1028 |
| Total params.: 983,716 |
| Trainable params.: 983,716 |
| Non-trainable params.: 0 |
Table 2.
Performance Metrics for Different Folds. Symbols: TA, TL, TP, TR, VA, VL, VP, VR, TeA, TeL, TeP, and TeR represent training accuracy, training loss, training precision, training recall, validation accuracy, validation loss, validation precision, validation recall, test accuracy, test loss, test precision, and test recall, respectively in percentages.
Table 2.
Performance Metrics for Different Folds. Symbols: TA, TL, TP, TR, VA, VL, VP, VR, TeA, TeL, TeP, and TeR represent training accuracy, training loss, training precision, training recall, validation accuracy, validation loss, validation precision, validation recall, test accuracy, test loss, test precision, and test recall, respectively in percentages.
| K | TA | TL | TP | TR | VA | VL | VP | VR | TeA | TeL | TeP | TeR |
|---|
| 1 | 96.31 | 0.1011 | 96.49 | 96.13 | 94.11 | 0.1820 | 94.37 | 93.99 | 94.28 | 0.1974 | 94.43 | 94.17 |
| 2 | 96.22 | 0.1010 | 96.39 | 96.04 | 94.01 | 0.1819 | 94.27 | 93.90 | 94.18 | 0.1972 | 94.33 | 94.07 |
| 3 | 96.31 | 0.1011 | 96.49 | 96.13 | 94.11 | 0.1820 | 94.37 | 93.99 | 94.28 | 0.1974 | 94.43 | 94.17 |
| 4 | 96.41 | 0.1012 | 96.59 | 96.23 | 94.20 | 0.1822 | 94.46 | 94.09 | 94.37 | 0.1976 | 94.52 | 94.26 |
| 5 | 96.51 | 0.1013 | 96.69 | 96.33 | 94.30 | 0.1824 | 94.56 | 94.19 | 94.47 | 0.1978 | 94.62 | 94.36 |
| 6 | 96.31 | 0.1135 | 96.49 | 96.13 | 94.10 | 0.1908 | 94.36 | 93.99 | 94.27 | 0.2029 | 94.42 | 94.16 |
| 7 | 96.81 | 0.1012 | 96.99 | 96.63 | 94.60 | 0.1781 | 94.86 | 94.49 | 94.77 | 0.2015 | 94.92 | 94.66 |
| 8 | 96.14 | 0.1176 | 96.32 | 95.96 | 93.93 | 0.2160 | 94.19 | 93.82 | 94.10 | 0.2101 | 94.25 | 93.99 |
| 9 | 96.64 | 0.1151 | 96.82 | 96.46 | 94.43 | 0.2135 | 94.69 | 94.32 | 94.60 | 0.1975 | 94.75 | 94.49 |
| 10 | 95.64 | 0.1201 | 95.82 | 95.46 | 93.43 | 0.2185 | 93.69 | 93.32 | 93.60 | 0.2025 | 93.75 | 93.49 |
| Average | 96.33 | 0.1073 | 96.51 | 96.15 | 94.12 | 0.1927 | 94.38 | 94.01 | 94.29 | 0.2002 | 94.44 | 94.18 |
Table 3.
Classification Report of 10th fold.
Table 3.
Classification Report of 10th fold.
| Class | Precision | Recall | F1-Score |
|---|
| Drusen | 0.94 | 0.95 | 0.94 |
| Normal | 0.95 | 0.94 | 0.95 |
| CNV | 0.95 | 0.90 | 0.92 |
| DME | 0.90 | 0.96 | 0.93 |
| Accuracy | | | 0.94 |
| Macro Avg | 0.94 | 0.94 | 0.94 |
| Weighted Avg | 0.94 | 0.94 | 0.94 |
Table 4.
Sensitivity and Specificity of 10th fold.
Table 4.
Sensitivity and Specificity of 10th fold.
| Class | Sensitivity | Specificity |
|---|
| DME | 0.989963 | 0.916084 |
| NORMAL | 0.99096 | 0.948488 |
| DRUSEN | 0.974254 | 0.925115 |
| CNV | 0.966781 | 0.974166 |
Table 5.
Interpretation of LIME results alongside input image and segmented image.
Table 6.
Adversarial Examples.
Table 7.
Comparative Analysis of COVID-19 Result to other SOTA methods.
Table 7.
Comparative Analysis of COVID-19 Result to other SOTA methods.
| Ref | Algorithm | Accuracy (%) | Parameters (Millions) |
|---|
| [35] | CNN-based CoroNet | 89.6 | 33.97 |
| [36] | Custom CNN | 94.53 | 34.73 |
| [37] | Attention based VGG | 85.43 | VGG-16 = 18 |
| | | | VGG-19 = 21.2 |
| [12] | Custom CNN | 95.94 | 3.7 |
| Proposed | Custom CNN | 97.18 | 0.983 |
Table 8.
Comparative Analysis of the Kidney Stone dataset.
Table 8.
Comparative Analysis of the Kidney Stone dataset.
| Ref | Algorithm | Accuracy (%) | Parameters (Millions) |
|---|
| [14] | Inception V3 | 61.6 | 22.32 |
| | VGG16 | 98.2 | 14.74 |
| | Resnet | 73.8 | 23.71 |
| | EANet | 77.02 | 6 |
| | Swin Transformers | 99.3 | 4.12 |
| | CCT | 96.54 | 4.07 |
| [38] | DenseNet201-Random Forest | 99.44 | 20 |
| [39] | VGG16NB | 96.26 | 14.74 |
| | DenseNet121-KNN | 96.64 | 20 |
| | VGG-DN-KNN | 100 | 14.74 |
| Proposed | Custom CNN | 99.70 | 0.983 |